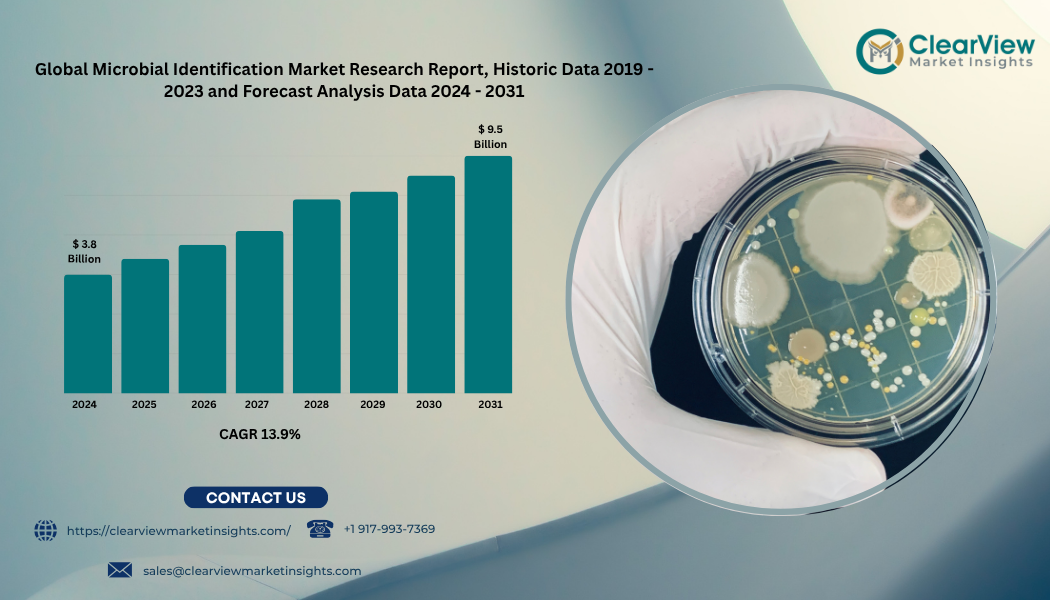

Gesponsert
Forestry Equipment Market Size, Share, Analysis, Key Players, Growth and Report 2024-2030
The report " Forestry Equipment Market by Felling Equipment (Chainsaw, Feller Buncher, Harvester, Others), by Extracting Equipment (Forwarder, Skidder, Others), by On-Site (Chippers and Grinders, Delimbers and Slashers, Others), by Other Forestry Equipment (Loaders, Mulchers, Others)- Global Forecasts to 2030"
The global Forestry equipment market is projected to reach USD 10,532.5 million in 2023, registering at a Compound Annual Growth Rate (CAGR) of 4.8% during the forecast period 2024-2030. The growth of the market is majorly driven by the increasing automation to boost the forestry equipment demand
Request sample report at https://www.precisionbusinessinsights.com/request-sample/?product_id=761245
Competitive Dashboard:
The prominent key players operating in the global forestry equipment market are Hitachi Construction Machinery Co. Ltd., Deere & Company, Epiroc AB, Sandvik AB, Volvo Construction Equipment, Liebherr international AG, Bell Equipment Limited, Caterpillar, Inc., Kesla Oyj, Rottne Industri AB
Regional Overview:
The report also examines the current concerns and their Future Effects on the Forestry Equipment Market by the region. The report covers all regions and countries, North America was the largest and Asia was the fastest-growing region in the Forestry Equipment Market. The market has been segmented into numerous primary regions and a detailed evaluation of primary countries.
- North America (U.S., Canada)
- Europe (Germany, U.K., France, Italy, Russia, Spain, Rest of Europe)
- Asia-Pacific (China, India, Japan, Australia, Southeast Asia, Rest of Asia Pacific)
- Latin America (Mexico, Brazil, Argentina, Columbia, Rest of Latin America)
- Middle East & Africa (GCC, Egypt, Nigeria, South Africa, Rest of Middle East and Africa)
A Few Points from the Table of Contents –
1. Executive Summary
2. Global Forestry Equipment Market Introduction
3. Global Forestry Equipment Market Dynamics
4. Global Forestry Equipment Market Analysis, 2019 - 2023 and Forecast 2024 – 2030
……………….
9. Global Forestry Equipment Market By Region, 2019 - 2023 and Forecast 2024 - 2030 (Sales Value USD Million)
10. North America Forestry Equipment Market, 2019 - 2023 and Forecast 2024 - 2030 (Sales Value USD Million)
11. Europe Forestry Equipment Market, 2019 - 2023 and Forecast 2024 - 2030 (Sales Value USD Million)
12. Asia Pacific (APAC) Forestry Equipment Market, 2019 - 2023 and Forecast 2024 - 2030 (Sales Value USD Million)
13. Middle East and Africa (MEA) Forestry Equipment Market 2019 - 2023 and Forecast 2024 - 2030 (Sales Value USD Million)
14. Latin America Forestry Equipment Market 2019 - 2023 and Forecast 2024 - 2030 (Sales Value USD Million)
15. Competition Landscape
16. Research Methodology
17. Appendix and Abbreviations
Scope of The Report:
- The forestry equipment market research report includes historical data, trending features, and market growth estimates for the future.
- The qualitative and quantitative analysis of the market along with CAGR calculation for the forecast period.
- The market report helps to provide the best results for business enhancement and business growth.
- The report gives a comprehensive overview of both primary and secondary data.
- The market key players covered here to help them strengthen their place in the market.
About Precision Business Insights:
We are a market research company that strives to provide the highest quality market research insights. Our diverse market research experts are enthusiastic about market research and therefore produce high-quality research reports. We have over 500 clients with whom we have a good business partnership and capacity to provide in-depth research analysis for more than 30 countries. In addition to delivering more than 150 custom solutions, we already have accounts with the top five medical device manufacturers.
Precision Business Insights offers a variety of cost-effective and customized research services to meet research requirements. We are a leading research service provider because of our extensive database built by our experts and the services we provide.
Contact:
Mr. Satya
Precision Business Insights | Toll Free: +1 866 598 1553
Email: sales@precisionbusinessinsights.com
Kemp House, 152 – 160 City Road, London EC1V 2NX
Web: https://precisionbusinessinsights.com/ | D U N S® Number: 852781747
Nach Verein filtern
Read More
Chicago, 29th May 2025 — Clearview Market Insights (CVMI) projects that the global microbial identification market will expand from USD 3.8 billion in 2024 to USD 9.5 billion by 2031, delivering a robust compound annual growth rate (CAGR) of 13.9 percent. The surge is fueled by escalating antimicrobial‑resistance (AMR) threats, stringent food‑safety mandates, decentralized clinical...
Online slots are becoming certainly one of typically the most used types of digital entertainment, attracting countless players worldwide. These games give you a thrilling mixture of luck, strategy, and excitement, making them a well liked among both casual gamers and serious bettors. Using their engaging themes, immersive graphics, and the chance of big wins, online slots have revolutionized...
